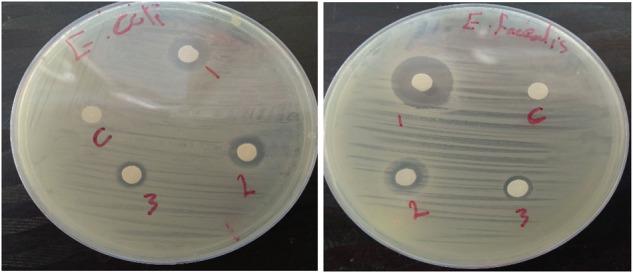
https://cdn.ncbi.nlm.nih.gov/pmc/blobs/1aa4/11799101/1aa714627a95/10856_2024_6851_Fig9_HTML.jpg

混合细菌培养法合成Ag-AgO纳米复合材料及其pH值对纳米复合材料尺寸和光学性质的影响
Ag-AgO nanocomposite biosynthesis by mixed bacterial cultivation and effect of the ph on size and optical properties of the nanocomposite.
作者信息
Al-Asbahi Morad G S S, Al-Ofiri Bashir A, Saad Fuad A A, Alnehia Adnan, Hadi Muhammad
机构信息
Department of Biology, Faculty of Sciences, Sana'a University, Sana'a, 12081, Yemen.
Department of Biology, Faculty of Applied Sciences, Thamar University, Dhamar, 87246, Yemen.
出版信息
J Mater Sci Mater Med. 2025 Feb 5;36(1):19. doi: 10.1007/s10856-024-06851-6.
This study examines the influence of pH on the energy band gap and crystallite size during the synthesis of a novel Ag-AgO nanocomposites through the mixed cultivation of Lactobacillus sp. and Bacillus sp. A range of analytical techniques, including X-ray Diffraction (XRD), UV-visible Spectroscopy (UV-vis), Fourier Transform Infrared Spectroscopy (FTIR), and Transmission Electron Microscopy (TEM), were employed to investigate the structural and optical characteristics of the nanocomposites. XRD analysis confirmed the presence of cubic phases of Ag and AgO, with crystallite sizes varying from 8 to 44 nm; notably, smaller crystallites were observed at a pH of 6.5. UV-vis spectroscopy indicated an energy band gap ranging from 1.83 to 1.897 eV, suggesting promising applications for the material. The optimal pH for synthesis, which yielded the smallest particle size as verified by TEM, was identified as 6.5. FTIR analysis revealed the presence of biologically derived coating agents that may enhance the immutability and bioactivity of the nanocomposite. Antibacterial assays demonstrated significant efficacy against Enterococcus faecalis(E. faecalis) and Escherichia coli, particularly highlighting its effectiveness against E. faecalis. Hemolytic assays confirmed the biocompatibility of the nanocomposite at lower concentrations. These findings indicate the potential applications of the biogenic Ag-AgO nanocomposites in medical and environmental fields, offering a sustainable solution to challenges associated with bacterial contamination. Future research may focus on integrating these biologically synthesized nanoparticles into advanced materials and coatings to improve their performance.
本研究通过乳酸杆菌属和芽孢杆菌属的混合培养,考察了pH值对新型Ag-AgO纳米复合材料合成过程中能带隙和微晶尺寸的影响。采用了一系列分析技术,包括X射线衍射(XRD)、紫外可见光谱(UV-vis)、傅里叶变换红外光谱(FTIR)和透射电子显微镜(TEM),来研究纳米复合材料的结构和光学特性。XRD分析证实了Ag和AgO立方相的存在,微晶尺寸在8至44nm之间变化;值得注意的是,在pH值为6.5时观察到较小的微晶。紫外可见光谱表明能带隙在1.83至1.897eV之间,表明该材料具有良好的应用前景。经TEM验证,合成的最佳pH值为6.5,此时产生的粒径最小。FTIR分析揭示了生物衍生涂层剂的存在,这些涂层剂可能会增强纳米复合材料的稳定性和生物活性。抗菌试验表明对粪肠球菌(E. faecalis)和大肠杆菌具有显著疗效,尤其突出了其对粪肠球菌的有效性。溶血试验证实了纳米复合材料在较低浓度下的生物相容性。这些发现表明生物源Ag-AgO纳米复合材料在医学和环境领域的潜在应用,为应对与细菌污染相关的挑战提供了一种可持续的解决方案。未来的研究可能集中于将这些生物合成的纳米颗粒整合到先进材料和涂层中,以提高其性能。